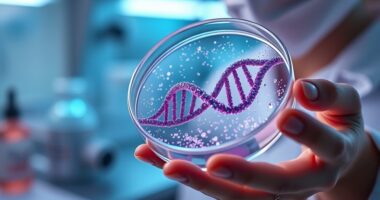

Red light therapy uses specific wavelengths of red and near-infrared light to penetrate your skin deeply, boosting cellular energy and promoting repair. It helps improve skin health, reduce inflammation, and support your body’s natural healing. Additionally, it can regulate your circadian rhythm, leading to better sleep, mood, and energy during the day. If you want to discover how this biohack can optimize your skin and mood, there’s more to explore below.
Key Takeaways
- Red light therapy uses specific wavelengths to penetrate skin and stimulate cellular repair, improving skin health and recovery.
- It boosts cellular energy production (ATP), supporting skin regeneration and overall cellular functions.
- Red light therapy helps regulate circadian rhythms, promoting better sleep, mood, and hormonal balance.
- Regular sessions can reduce inflammation, enhance immunity, and improve mood and energy levels naturally.
- It offers a science-backed, non-invasive biohack to optimize skin health and internal biological processes.

Red light therapy is a non-invasive treatment that uses specific wavelengths of red and near-infrared light to promote healing and improve overall health. When you step into a session, these wavelengths penetrate your skin deeply, reaching cells at the microscopic level. This process kickstarts cellular regeneration, stimulating your body’s natural repair mechanisms. As your cells absorb the light, they produce more adenosine triphosphate (ATP), the energy currency that fuels cellular functions. This boost in energy enhances your skin’s ability to repair itself, leading to smoother, healthier skin, and supports recovery from injuries. Beyond skin health, this cellular regeneration can bolster your immune response and reduce inflammation, making you feel more energized and resilient.
Red light therapy stimulates cellular repair, boosts energy, and promotes healthier skin and resilience.
In addition to promoting cellular regeneration, red light therapy plays an essential role in circadian regulation. Your body’s internal clock, the circadian rhythm, governs sleep-wake cycles, hormone release, and other crucial processes. Exposure to specific wavelengths of red and near-infrared light can help synchronize your circadian rhythm, especially if it’s disrupted by irregular schedules, artificial lighting, or stress. When your circadian regulation is optimized, you experience better sleep quality, improved mood, and increased alertness during the day. This light therapy mimics natural sunlight in a controlled way, signaling your brain to produce melatonin at the right time and helping reset your internal clock.
You might notice that consistent red light therapy sessions leave you feeling more balanced and alert, especially if you’re dealing with jet lag, shift work, or seasonal affective disorder. The light’s influence on circadian regulation aligns your internal processes with natural day-night cycles, leading to more restful sleep and a more stable mood. It’s like resetting your biological clock to a healthier rhythm, which can have profound effects on your overall well-being. Additionally, understanding the cellular processes involved can help you appreciate how this therapy supports your body’s innate healing abilities.
As you incorporate red light therapy into your routine, you’re not just supporting skin health but also enhancing your body’s internal timing and regenerative capacity. It’s a powerful biohack that taps into your body’s innate ability to heal and adapt. With regular sessions, you may find yourself feeling more energized, sleeping better, and experiencing an uplifted mood. This therapy offers a simple, drug-free way to optimize your biological functions, making it a valuable addition to your health regimen. Whether you’re aiming for better skin, improved mood, or a more balanced circadian rhythm, red light therapy provides a scientifically backed approach to achieving those goals naturally.

Red Light Therapy for Face and Body, Red Infrared Light Therapy Lamp with Stand Led 660nm Red Light-Therapy& 850nm Infrared Light Device for Body
RED LIGHT THERAPY LAMPS DEVICE: Viconor red light therapy lamp has 120 LEDs light, each light includes 1…
As an affiliate, we earn on qualifying purchases.
As an affiliate, we earn on qualifying purchases.
Frequently Asked Questions
How Long Does It Take to See Results From Red Light Therapy?
When you start red light therapy, timing expectations vary, but most notice visible improvements within a few sessions. Typically, you might see some benefits after 2 to 4 weeks of consistent use. Keep in mind, individual results depend on factors like skin type and treatment frequency. Stay patient and committed, and you’ll likely experience gradual enhancements in skin health, mood, and overall well-being over time.
Are There Any Known Side Effects or Risks?
You might wonder if red light therapy has safety concerns or long-term effects. Generally, it’s safe when used as directed, with minimal risks. However, some people could experience minor side effects like eye strain or skin irritation. Currently, there’s limited data on long-term effects, so it’s wise to consult a healthcare professional, especially if you have underlying conditions. Stay cautious and follow recommended guidelines for safe, effective use.
Can Red Light Therapy Be Combined With Other Treatments?
You can combine red light therapy with other treatments, but it’s important to consider combination protocols for optimal results. Using treatment synergy, such as pairing it with skincare routines or physical therapies, can enhance benefits. Always consult your healthcare provider before combining treatments to ensure safety and effectiveness. When done correctly, combining red light therapy with other methods can boost overall skin health and mood improvements.
What Specific Skin Conditions Can It Help Improve?
You might think red light therapy’s only for sci-fi skin cures, but it actually targets real issues like acne and signs of aging. It boosts collagen for anti-aging benefits and reduces inflammation, making your skin look fresher. While it’s not a miracle for every skin condition, many find it helpful for improving texture and clarity. So, if you’re after clearer, younger-looking skin, it’s worth giving it a shot.
Is Red Light Therapy Suitable for All Skin Types?
You wonder if red light therapy suits your skin type. Generally, it’s compatible with most skin types due to its gentle, non-invasive nature. However, skin compatibility and treatment customization are essential, so check with a professional to guarantee safety. People with darker skin tones or specific skin conditions should consult a dermatologist. Overall, red light therapy is versatile, but personalized adjustments help optimize its benefits for your skin.

Red Light Therapy for Face and Body, Red Infrared Light Therapy Lamp with Stand Led 660nm Red Light-Therapy& 850nm Infrared Light Device for Body
RED LIGHT THERAPY LAMPS DEVICE: Viconor red light therapy lamp has 120 LEDs light, each light includes 1…
As an affiliate, we earn on qualifying purchases.
As an affiliate, we earn on qualifying purchases.
Conclusion
Imagine your skin and mood as a garden needing just the right sunlight to flourish. Red light therapy acts like a gentle sunbeam, boosting your cells’ energy and brightening your outlook. Studies show it can improve skin health and lift spirits in as little as a few sessions. Just like tending to a garden, a little consistent care can transform your well-being, making you feel renewed, vibrant, and ready to thrive.

Red Light Therapy Sleep, Red Night Lights With 670nm Wavelength, Touch Control with 3 Distinct Color Modes, For Support Deep Relaxation and Improve Sleeping for Adult & Kid Bedroom, Gift
【Red Light Therapy for Sleep】Unlike a simple red lightbulb,Our red light therapy device is precisely calibrated to emit…
As an affiliate, we earn on qualifying purchases.
As an affiliate, we earn on qualifying purchases.

Red Light Therapy Pad for Body Back Knee Shoulder Hands Feet Portable 660nm 850nm Home Use 3 Chips in 1 Infrared Light Heating Wrap Belt Gift for Women Men (Corded)
bonodave Corded Red Light Pad: It with light heating function can warm body up, supports 10HZ pulse mode…
As an affiliate, we earn on qualifying purchases.
As an affiliate, we earn on qualifying purchases.